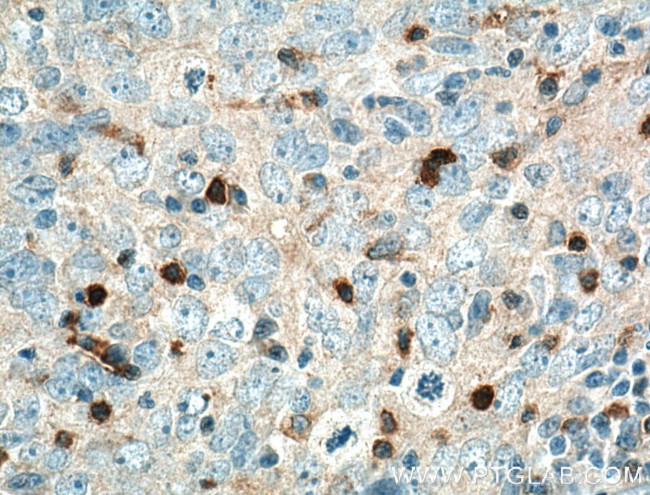
KIF22 Antibody in Immunohistochemistry (Paraffin) (IHC (P))

Search
Proteintech
KIF22 Polyclonal Antibody
{{$productOrderCtrl.translations['antibody.pdp.commerceCard.promotion.promotions']}}
{{$productOrderCtrl.translations['antibody.pdp.commerceCard.promotion.viewpromo']}}
{{$productOrderCtrl.translations['antibody.pdp.commerceCard.promotion.promocode']}}: {{promo.promoCode}} {{promo.promoTitle}} {{promo.promoDescription}}. {{$productOrderCtrl.translations['antibody.pdp.commerceCard.promotion.learnmore']}}
产品信息
13403-1-AP
种属反应
已发表种属
宿主/亚型
分类
类型
抗原
偶联物
形式
浓度
规格
纯化类型
保存液
内含物
保存条件
运输条件
产品详细信息
Immunogen sequence: GGSTQQRRR EMAAASAAAI SGAGRCRLSK IGATRRPPPA RVRVAVRLRP FVDGTAGASD PPCVRGMDSC SLEIANWRNH QETLKYQFDA FYGERSTQQD IYAGSVQPIL RHLLEGQNAS VLAYGPTGAG KTHTMLGSPE QPGVIPRALM DLLQLTREEG AEGRPWALSV TMSYLEIYQE KVLDLLDPAS GDLVIREDCR GNILIPGLSQ KPISSFADFE RHFLPASRNR TVGATRLNQR SSRSHAVLLV KVDQRERLAP FRQREGKLYL IDLAGSEDNR RTGNKGLRLK ESGAINTSLF VLGKVVDALN QGLPRVPYRD SKLTRLLQDS LGGSAHSILI ANIAPERRFY L (4-353 aa encoded by BC028155)
靶标信息
The protein encoded by this gene is a member of kinesin-like protein family. This family of proteins are microtubule-dependent molecular motors that transport organelles within cells and move chromosomes during cell division. The C-terminal half of this protein has been shown to bind DNA. Studies with the Xenopus homolog suggests its essential role in metaphase chromosome alignment and maintenance.
仅用于科研。不用于诊断过程。未经明确授权不得转售。
生物信息学
蛋白别名: kinesin family member 22A; kinesin-like 4; Kinesin-like DNA-binding protein; kinesin-like DNA-binding protein pseudogene; Kinesin-like protein 4; Kinesin-like protein KIF22; origin of plasmid DNA replication-binding protein; oriP binding protein; unnamed protein product
基因别名: A-328A3.2; AU021460; C81217; KID; KIF22; Kif22a; KNSL4; OBP; OBP-1; OBP-2; SEMDJL2
UniProt ID: (Human) Q14807, (Rat) Q5I0E8, (Mouse) Q3V300
Entrez Gene ID: (Human) 3835, (Rat) 293502, (Mouse) 110033